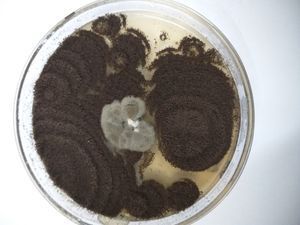

Mucor Species observed under Foldscope
 Mar 27, 2019 • 11:15 PM UTC
Mar 27, 2019 • 11:15 PM UTC Unknown Location
Unknown Location 140x Magnification
140x Magnification Microorganisms
Microorganisms
Dr. Mooventhan Palanisamy
I am Dr. Mooventhan Palanisamy, currently serving as a Senior Scientist (Agricultural Extension) in the Agricultural Research Service (ARS) under the Indian Council of Agricultural Research (ICAR), India.
173posts
24comments
1locations

View in Media Gallery
Mucor is a filamentous fungus found in soil, plants,
decaying fruits and vegetables. As well as being ubiquitous in nature and a
common laboratory contaminant, Mucor spp. may cause infections in man,
frogs, amphibians, cattle, and swine.
decaying fruits and vegetables. As well as being ubiquitous in nature and a
common laboratory contaminant, Mucor spp. may cause infections in man,
frogs, amphibians, cattle, and swine.

??

View in Media Gallery
??

View in Media Gallery
Sign in to commentNobody has commented yet... Share your thoughts with the author and start the discussion!

 0 Applause
0 Applause 0 Comments
0 Comments

















